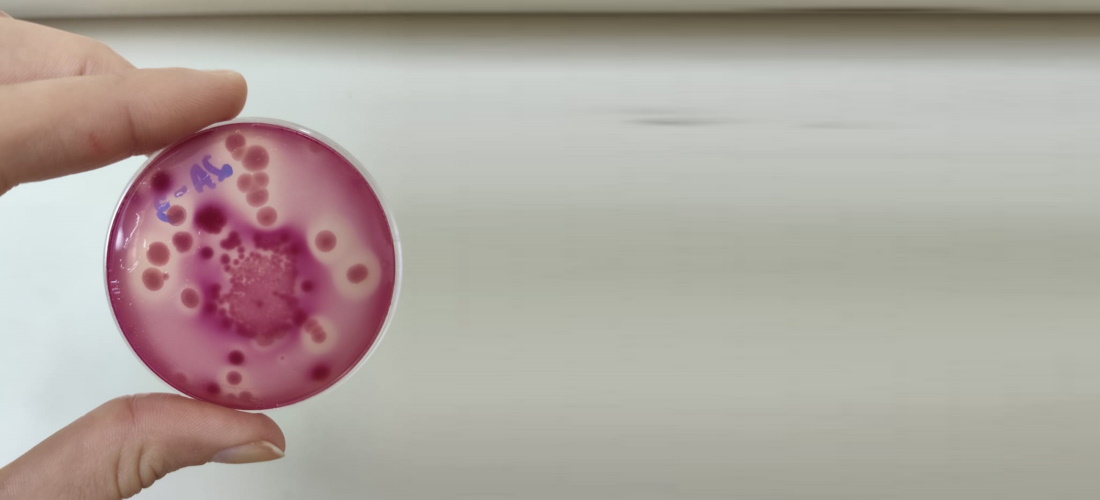

- Gabinete da Chefia do Executivo
- Coordenadoria Estadual da Mulher - CEM
- Secretaria Executiva da Casa Militar
- Gabinete do Vice-Governador
- Procuradoria Geral do Estado
- Secretaria de Estado da Administração
- Secretaria de Estado da Casa Civil
- Secretaria de Estado de Comunicação
- Secretaria Executiva de Articulação Nacional
- Secretaria de Estado da Justiça e Cidadania
- Secretaria Especial de Articulação Internacional
- Secretaria de Estado da Fazenda
- Secretaria de Estado da Segurança Pública
- Secretaria de Estado do Planejamento
- Secretaria de Estado da Agricultura e Desenv. Rural
- Secretaria de Estado de Assist. Social, Trab. e Habitação
- Secretaria de Estado do Desenv. Econômico Sustentável
- Secretaria de Estado da Educação
- Secretaria de Estado da Infra-estrutura
- Secretaria de Estado Turismo, Cultura e Esporte
- Secretaria de Estado da Saúde
- Secretarias de Estado de Desenvolvimento Regionais
- AGESC Agência Reguladora de Serviços Públicos de SC
- APSFS Administração do Porto de São Francisco do Sul
- BADESC Agência de Fomento do Estado de SC
- BESCOR Besc S/A Corretora de Seguros e Adm. de Bens
- CELESC Centrais Elétricas de Santa Catarina
- CEASA Centrais de Abastecimento do Estado de SC
- CEPA Centro de Socioeconomia e Planejamento Agrícola
- CIASC Centro de Informática e Automação do Estado de SC
- CASAN Companhia Catarinense de Águas e Saneamento
- CODESC Companhia de Desenvolvimento do Estado de SC
- COHAB Companhia de Habitação do Estado de SC
- CIDASC Cia Integrada de Desenvolvimento Agrícola de SC
- DEINFRA Departamento Estadual de Infra-Estrutura
- DETER Departamento de Transportes e Terminais
- DETRAN Departamento Est. de Trânsito e Seg. Viária
- EPAGRI Empresa Pesq. Agropecuária e Extensão Rural SC
- FAPESC Fund. Apoio Pesquisa Científica e Tecnológica SC
- FCC Fundação Catarinense de Cultura
- FESPORTE Fundação Catarinense de Desportos
- FCEE Fundação Catarinense de Educação Especial
- FATMA Fundação do Meio Ambiente
- IPREV Instituto de Previdência do Estado de SC
- IMETRO Inst. Metrologia, Normatização e Qualidade Indl
- JUCESC Junta Comercial do Estado de Santa Catarina
- Portal do Servidor Público Estadual
- SANTUR Santa Catarina Turismo S.A.
- SC PARCERIAS SC Parcerias S.A.
- SCGÁS Companhia de Gás de Santa Catarina
- UDESC Universidade do Estado de Santa Catarina